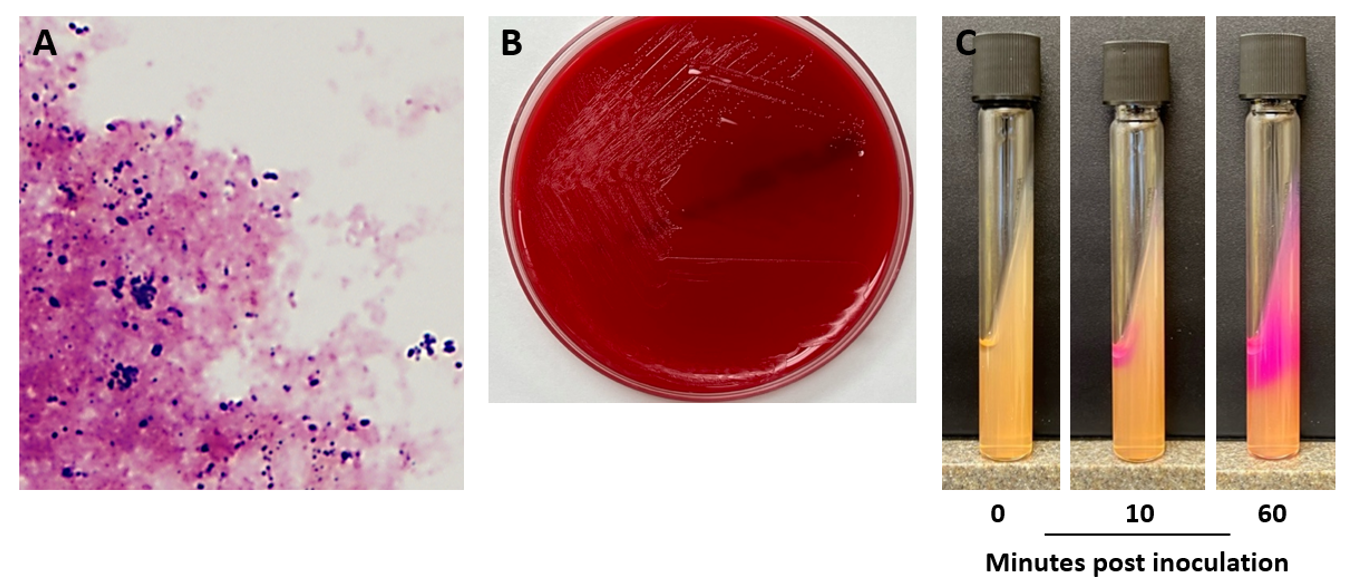

Case history
A middle-aged female with a one-year history of obstructive pyelonephrosis caused by a large nephrolith was admitted for a percutaneous nephrolithotomy and cystolitholapaxy. Previous medical history was notable for hypertension, type 2 diabetes, and peripheral vascular disease. A previously placed stent and nephrostomy tube had become encrusted, necessitating surgical intervention. CT imaging demonstrated moderate hydronephrosis, progressive encrustation of the stent, and high stone burden. Pre-operative urine cultures yielded greater than 3 organisms of unclear significance. Intraoperative findings revealed a calcified stent and large renal pelvic matrix stone which was removed and sent for culture and mineral analysis.
Laboratory identification
Intraoperative specimens were sent to the microbiology laboratory for routine culture. Gram stain of the nephrolith and associated tissue was performed, revealing gram positive coryneform rods and gram positive cocci (Image 1A). Light growth of Enterococcus faecalis was observed after 24 hours, along with a heavy amount of pinpoint, gram positive rods (Image 1B). It was noted that growth was only observed on blood agar (not chocolate agar), a feature suggestive of a lipophilic species of Corynebacterium. Colonies were visible on blood agar after prolonged incubation, and the organism was determined to catalase positive. The organism produced copious amounts of urease, leading to tube positivity within 10 minutes (Image 1C). The organism was definitively identified by MALDI-TOF MS as Corynebacterium urealyticum.
Discussion
Corynebacterium urealyticum is a lipophilic corynebacterial species frequently recovered from the urinary tracts of patients with renal or urological disease. While this organism is often associated with alkaline encrusted cystitis, it also plays an important role in renal stone formation. Due to its indolent and slow growing nature, the organism can be challenging to recover from routine urine cultures; thus, disease burden attributable to C. urealyticum is likely underestimated. Risk factors for disease include patients with urinary tract abnormalities, catheterization, prolonged hospitalization, history of immunocompromising conditions or renal transplant, and extended therapy with broad-spectrum antibiotics.1 Indeed, most contemporary clinical isolates are multidrug resistant, making antibiotic therapy of C. urealyticum challenging.
C. urealyticum is a member of the colonizing flora of both the skin and the urinary tract, and its ability to adhere to the uroepithelium is believed to mediate its ability to cause disease. The organism is frequently detected in the groin of hospitalized and institutionalized patients.2 As a member of the lipophilic corynebacteria, enhanced growth can be achieved through the addition of 0.1% Tween 80 to culture media. The impressive urease activity of C. urealyticum is central to pathogenesis as hydrolysis of urea in the GU tract leads to ammonia production and alkalinization (Image 1C). This, in turn, leads to saturation of the microenvironment with calcium phosphate and struvite crystallization which can result in sone formation.1 In settings where C. urealyticum infection may be suspected (including encrusted cystitis and encrusted pyelitis), prospective discussions with the laboratory are warranted to avoid dismissal of the organism as a diphtheroid bacilli that is a normal component of the urogenital flora. This is particularly important if the laboratory does not routinely hold cultures for longer than 24 hours.
Chronic and recurrent urinary tract infections in patients of advanced age is usually the primary presentation of C. urealyticum infection. By contrast, encrusted uropathies can develop in 4-16% of patients with C. urealyticum bacteruria and are subacute-to-chronic conditions associated with urease-producing bacteria.2 C. urealyticum is the principal cause of encrusted uropathies. This case represents a more complex case of encrusted disease leading to extensive nephrolith formation requiring surgical intervention. For urinary tract infections, vancomycin remains the antibiotic of choice for management in addition to removal of the impacted mucosal encrustations and urological consultation.3 C. urealyticum also exhibits near uniform susceptibility to linezolid. The excised nephrolith in this patient’s case was found to be composed of 90% struvite and 10% calcium phosphate. Following the procedure, imaging revealed no visible, residual stones in either the impacted kidney, ureter, or bladder. The patient is followed as an outpatient and continues to do well.
References
- Salem, N., Salem, L., Saber, S., Ismail, G., and Bluth, M.H. Corynebacterium urealyticum: a comprehensive review of an understated organism. Infect. Drug Resist. 2015:8 129-145.
- Van de Perre, E., Reichman, G., De Geyter, D., Geers, C., Wissing, K.M., and Letavernier, E. Encrusted uropathy: a Comprehensive Overview – to the Bottom of the Crust. Front. Med. 2021. 7:609024
- Kim, R. and Reboli, A.C. Chapter 205: Other Coryneform Bacteria, Arcanobacterium haemolyticum, and Rhodococci in Mandell, Douglas and Bennett’s Principals and Practice of Infectious Diseases 9th Ed. Elsevier, Philadelphia, PA. Pgs: 2532-2542.

-Andrew Clark, PhD, D(ABMM) is an Assistant Professor at UT Southwestern Medical Center in the Department of Pathology, and Associate Director of the Clements University Hospital microbiology laboratory. He completed a CPEP-accredited postdoctoral fellowship in Medical and Public Health Microbiology at National Institutes of Health, and is interested in antimicrobial susceptibility and anaerobe pathophysiology.

-Clare McCormick-Baw, MD, PhD is an Assistant Professor of Clinical Microbiology at UT Southwestern in Dallas, Texas. She has a passion for teaching about laboratory medicine in general and the best uses of the microbiology lab in particular.
Having just read the microbiology case study about the middle-aged female undergoing nephrolithotomy with an encrusted stent on the Lab Medicine Blog, I’m fascinated by the intricacies of this medical scenario. The case study delves into the challenges posed by infections in specialized procedures, shedding light on the importance of microbiological analysis. The details provided in the study are thorough, and it’s evident that the authors have a strong grasp of the subject matter. This case study serves as a great learning opportunity for medical professionals, offering insights into diagnosis, treatment, and prevention strategies. Kudos to the Lab Medicine Blog for sharing such a relevant and informative piece that contributes to the advancement of medical knowledge.